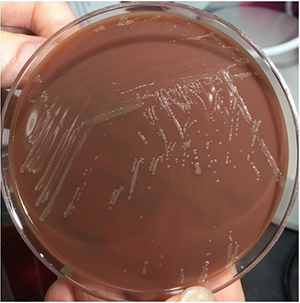

August 2022
Clinical History
A man in his late 40's with a history of Bruton's agammaglobulinemia on monthly IVIG presented to the ER with one week of right pleuritic and substernal chest pain with associated cough and fever. He was previously healthy with no issues breathing, no prodromal viral symptoms, nor any sick contacts. After developing exertional dyspnea, he had progressive dry cough, worsening chest pain, and fevers to 100.4F. An outpatient chest x-ray several days prior showed new right pleural effusion. Due to worsening symptoms, he eventually came to Cedars-Sinai ER.
While in the ER, he had fevers up to 100.3F with a white blood cell count of 15,000/UL on admission. A chest tube was placed and drained exudative pleural fluid. Two sets of blood cultures were collected and sent to microbiology for testing.

Fig. 1: Gram stain showing the thin gram-negative rods Campylobacter fetus.
Fig 2: Chocolate agar plate growing Campylobacter fetus

Fig 3: Kirby-Bauer susceptibility showing that this strain of Campylobacter fetus is highly susceptible to the antibiotics tested.
Blood culture:
The aerobic bottle from both blood cultures grew a thin gram-negative rod after 3 days of incubation. (fig. 1) The organism grew best on chocolate agar at 35*C in a CO2 enriched environment and was identified by MALDI-TOF as Campylobacter fetus. (fig. 2) Susceptibility testing was requested by the physician, so an isolate was sent to ARUP Laboratories for testing. A non-standardized Kirby-Bauer susceptibility based on published data was performed to supply preliminary information. The C. fetus was susceptible to multiple antibiotics including ampicillin, tetracycline, levofloxacin, meropenem and ceftriaxone (fig. 3).
Clinical Course:
The patient was started on empiric vancomycin and piperacillin-tazobactam which was later switched to IV ceftriaxone after identification of Campylobacter fetus. His symptoms gradually began improving and his chest tube was removed.
Discussion
Bruton's agammaglobulinemia, also known as X-linked agammaglobulinemia, is an inherited immunodeficiency disorder with germline mutations in the gene which encodes for Bruton's tyrosine kinase. As the name suggests, the gene is located on the X chromosome, leading to the disease manifesting near exclusively in males with females being asymptomatic carriers. Bruton's tyrosine kinase plays an essential role in the maturation of B cells in the bone marrow, thus individuals afflicted by this condition have depleted mature B cells, including plasma cells which normally produce antibodies. Due to the lack of antibodies, these patients are immunodeficient and have increased susceptibility to infections. Treatment for Bruton's agammaglobulinemia is intravenous immunoglobulin at regular intervals to boost the patient's immune system.
The humoral immunodeficiency in these patients not only results in increased risk of infections, but also infections with rare organisms. Campylobacter fetus is a gram-negative rod bacterium which infrequently infects humans, usually only in the setting of the elderly or immunocompromised. Typical infections with C. fetus manifests as diarrheal illness. C. fetus bacteremia presenting as empyema, as in this patient, is exceptionally rare but has been described with other Campylobacter species. While there are studies looking at antimicrobial susceptibility of this species, there is currently no CLSI guidelines for the performance and interpretation of susceptibility testing.
References
- Tremblay C, Gaudreau C, Lorange M. Epidemiology and antimicrobial susceptibilities of 111 Campylobacter fetus subsp. fetus strains isolated in Québec, Canada, from 1983 to 2000. J Clin Microbiol. 2003 Jan;41(1):463-6. doi: 10.1128/JCM.41.1.463-466.2003. PMID: 12517895; PMCID: PMC149556.
- Wagenaar JA, van Bergen MA, Blaser MJ, Tauxe RV, Newell DG, van Putten JP. Campylobacter fetus infections in humans: exposure and disease. Clin Infect Dis. 2014 Jun;58(11):1579-86. doi: 10.1093/cid/ciu085. Epub 2014 Feb 18. PMID: 24550377.